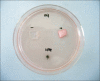

In vitro physical, chemical, and biological evaluation of commercially available metal orthodontic brackets
- PMID: 23323244
- PMCID: PMC3542450
- DOI: 10.4041/kjod.2012.42.6.297
In vitro physical, chemical, and biological evaluation of commercially available metal orthodontic brackets
Abstract
Objective: This in vitro study was undertaken to evaluate the physical, chemical, and biological properties of commercially available metal orthodontic brackets in South Korea, because national standards for these products are lacking.
Methods: FOUR BRACKET BRANDS WERE TESTED FOR DIMENSIONAL ACCURACY, (MANUFACTURING ERRORS IN ANGULATION AND TORQUE), CYTOTOXICITY, COMPOSITION, ELUTION, AND CORROSION: Archist (Daeseung Medical), Victory (3M Unitek), Kosaka (Tomy), and Confidence (Shinye Odontology Materials).
Results: The tested rackets showed no significant differences in manufacturing errors in angulation, but Confidence brackets showed a significant difference in manufacturing errors in torque. None of the brackets were cytotoxic to mouse fibroblasts. The metal ion components did not show a regular increasing or decreasing trend of elution over time, but the volume of the total eluted metal ions increased: Archist brackets had the maximal Cr elution and Confidence brackets appeared to have the largest volume of total eluted metal ions because of excessive Ni elution. Confidence brackets showed the lowest corrosion resistance during potentiodynamic polarization.
Conclusions: The results of this study could potentially be applied in establishing national standards for metal orthodontic brackets and in evaluating commercially available products.
Keywords: Corrosion; Cytotoxicity; Elution; Orthodontic brackets.
Conflict of interest statement
The authors report no commercial, proprietary, or financial interest in the products or companies described in this article.
Figures

Similar articles
-
Comparison of Galvanic Currents Generated Between Different Combinations of Orthodontic Brackets and Archwires Using Potentiostat: An In Vitro Study.J Int Oral Health. 2015 Jul;7(7):29-35. J Int Oral Health. 2015. PMID: 26229367 Free PMC article.
-
A stainless steel bracket for orthodontic application.Eur J Orthod. 2005 Jun;27(3):237-44. doi: 10.1093/ejo/cji005. Eur J Orthod. 2005. PMID: 15947222
-
Ion Release and Galvanic Corrosion of Different Orthodontic Brackets and Wires in Artificial Saliva.J Contemp Dent Pract. 2017 Mar 1;18(3):222-227. J Contemp Dent Pract. 2017. PMID: 28258269
-
Galvanic Corrosion of and Ion Release from Various Orthodontic Brackets and Wires in a Fluoride-containing Mouthwash.J Dent Res Dent Clin Dent Prospects. 2015 Summer;9(3):159-65. doi: 10.15171/joddd.2015.030. Epub 2015 Sep 16. J Dent Res Dent Clin Dent Prospects. 2015. PMID: 26697148 Free PMC article.
-
Torque value accuracy of preadjusted metal brackets for upper and lower incisors.Minerva Stomatol. 2019 Feb;68(1):31-35. doi: 10.23736/S0026-4970.18.04148-1. Minerva Stomatol. 2019. PMID: 30667202
Cited by
-
Antibacterial activity and effect on gingival cells of microwave-pulsed non-thermal atmospheric pressure plasma in artificial saliva.Sci Rep. 2017 Aug 21;7(1):8395. doi: 10.1038/s41598-017-08725-0. Sci Rep. 2017. PMID: 28827766 Free PMC article.
-
Assessment of dimensional accuracy of preadjusted metal injection molding orthodontic brackets.Dent Res J (Isfahan). 2016 Sep;13(5):440-445. doi: 10.4103/1735-3327.192299. Dent Res J (Isfahan). 2016. PMID: 27857770 Free PMC article.
References
-
- Creekmore TD, Kunik RL. Straight wire: the next generation. Am J Orthod Dentofacial Orthop. 1993;104:8–20. - PubMed
-
- Ødegaard J, Segner D. Shear bond strength of metal brackets compared with a new ceramic bracket. Am J Orthod Dentofacial Orthop. 1988;94:201–206. - PubMed
-
- Feldner JC, Sarkar NK, Sheridan JJ, Lancaster DM. In vitro torque-deformation characteristics of orthodontic polycarbonate brackets. Am J Orthod Dentofacial Orthop. 1994;106:265–272. - PubMed
-
- Cacciafesta V, Sfondrini MF, Scribante A, Klersy C, Auricchio F. Evaluation of friction of conventional and metal-insert ceramic brackets in various bracket-archwire combinations. Am J Orthod Dentofacial Orthop. 2003;124:403–409. - PubMed
-
- Kapur Wadhwa R, Kwon HK, Sciote JJ, Close JM. Frictional resistance in ceramic and metal brackets. J Clin Orthod. 2004;38:35–38. - PubMed
LinkOut - more resources
Full Text Sources